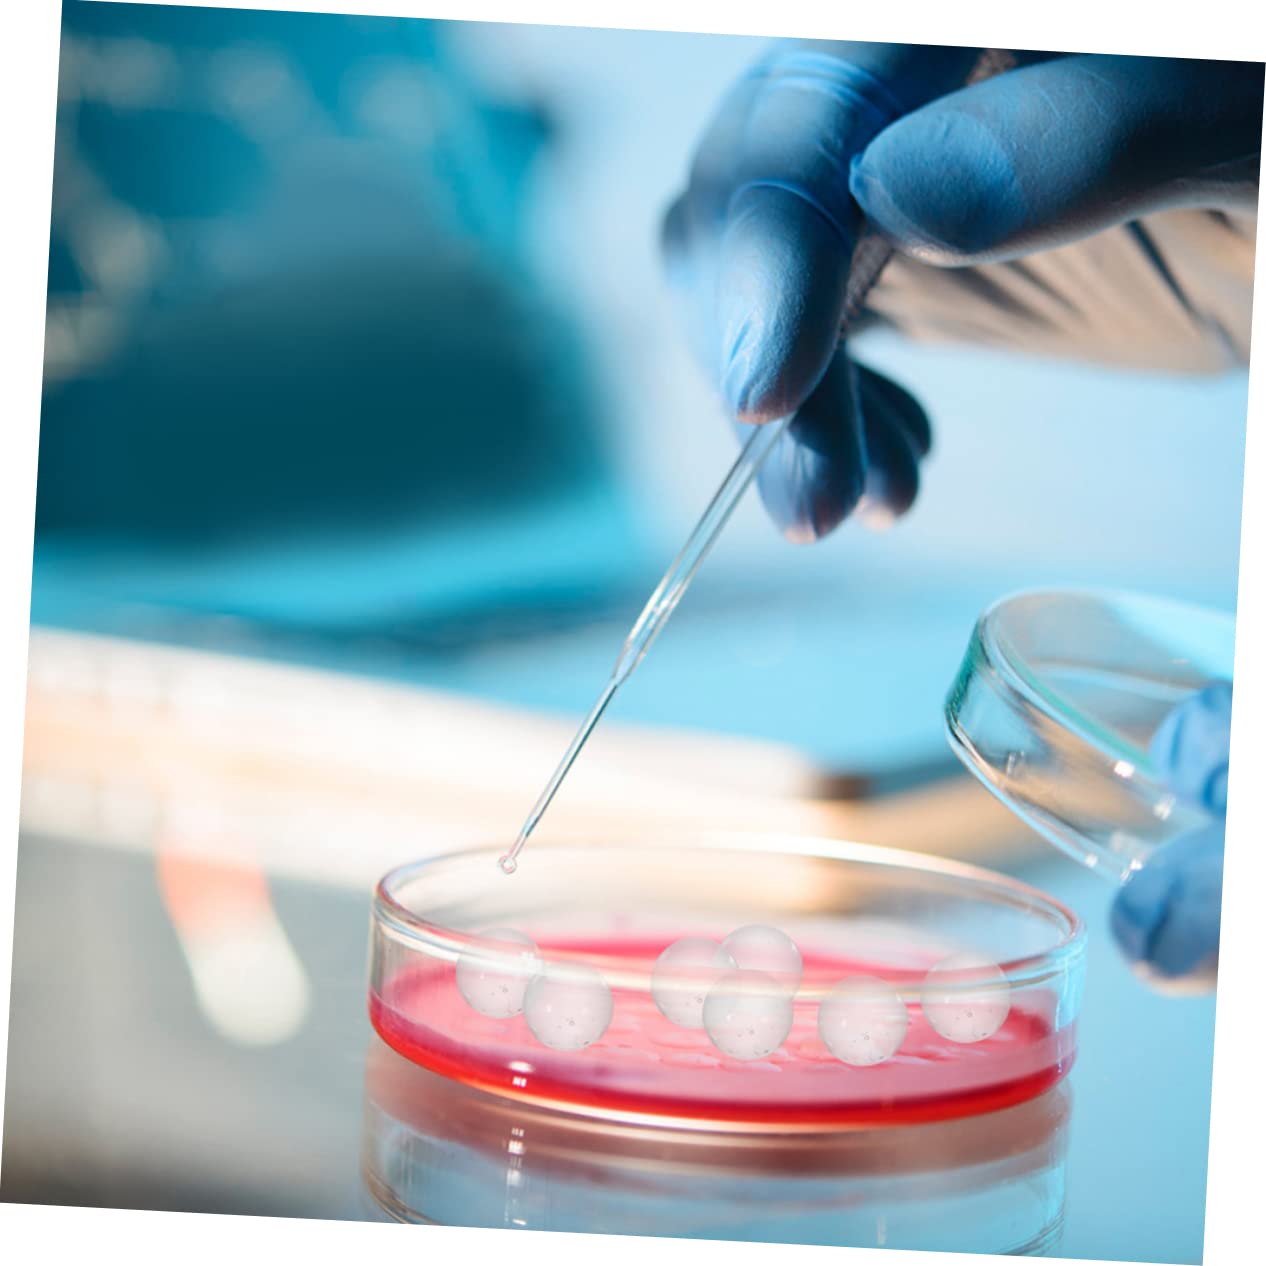

Brand:
Sfera di trasparente solida: semplice nel design, ma pratica per l'uso in laboratorio chimico, con una quantità sufficiente, può facilmente soddisfare le diverse esigenze, sfera di Sfera di trasparente: la sfera di trasparente è facile da usare, piccola e compatta, ti offre molta comodità, sfera di trasparente Sfera di trasparente solida: superficie liscia, elevata durezza, non facile da deformare o rompere e utile mini sfera di Sfera di solida: materiale di alta qualità, che corrode o corrode e ha una sfera di Sfera di solida: elevata durezza, utile ed eccellente, superficie liscia, struttura fine, buona sensazione tatto, piccola sfera di
EAN:
Categorie
Biglie
